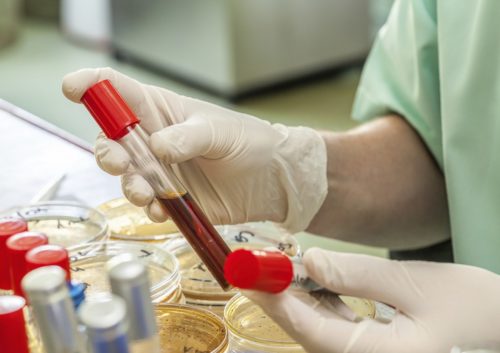

Эритроциты и гемоглобин
Красные кровяные тельца, именуемые эритроцитами (RBC) – многочисленный клеточный компонент крови. Их функция заключается в переносе кислорода и оксида углерода. RBC образуются в красном костном мозге, расположенном внутри костей черепа, позвоночника и в ребрах. Как избыток, так и недостаток клеток говорит о возникших проблемах в организме человека. На заметку!Гемоглобин – это железосодержащий белок, входящий в состав эритроцитов. Он доставляет кислород от легких к клеткам, а образовавшийся углекислый газ переносит в легкие, где он выдыхается. Когда уровень гемоглобина падает, подача кислорода к клеткам замедляется.
Первые признаки низкого Hb:
- бледность кожного покрова;
- слабость;
- головокружение;
- сухость кожи;
- ломкость ногтей.
Возможны различные проявления чувства голода. Причиной являются острые (во время операции) или хронические (обильные менструации) кровопотери, скрытые кровотечения (при язве желудка, геморрое и других болезнях). Это может быть недостаток железа, необходимого для синтеза гемоглобина.
Повышенный уровень гемоглобина также опасен для здоровья. Избыток клеток эритроцитов сгущает кровь, нарушает ее свойства. Основные симптомы повышенного Hb:
- частые головные боли;
- утомляемость, сонливость;
- носовые кровотечения;
- появление румянца на лице.
Чаще всего человек ощущает обезвоживание организма, которому способствует не только жара, но и лихорадка, рвота, диарея.
Врачи отмечают, что проверка уровня гемоглобина в домашних условиях может быть полезной для мониторинга состояния здоровья. Существуют различные способы, включая использование портативных анализаторов, которые позволяют получить результаты всего за несколько минут. Такие устройства работают на основе капиллярной крови и могут быть достаточно точными, если следовать инструкциям.
Однако специалисты подчеркивают, что домашние тесты не могут полностью заменить лабораторные исследования. Они рекомендуют периодически проходить полное обследование в медицинском учреждении, особенно если есть подозрения на анемию или другие заболевания. Важно также учитывать, что уровень гемоглобина может колебаться в зависимости от времени суток, питания и физической активности. Поэтому для более точной оценки состояния здоровья врачи советуют вести дневник самоконтроля и обсуждать результаты с лечащим врачом.

Врачи отмечают, что проверка уровня гемоглобина в домашних условиях становится все более доступной благодаря современным технологиям. Существуют специальные портативные анализаторы, которые позволяют быстро и точно измерить этот показатель. Такие устройства работают на основе капиллярного анализа крови и могут дать результат всего за несколько минут.
Однако специалисты подчеркивают, что хотя домашние тесты удобны, они не могут полностью заменить лабораторные исследования. Важно помнить, что уровень гемоглобина может колебаться в зависимости от времени суток, питания и физической активности. Поэтому для более точной диагностики и оценки состояния здоровья рекомендуется периодически проходить обследования в медицинских учреждениях. Врачи советуют также обращать внимание на симптомы анемии, такие как усталость, слабость и бледность кожи, и при их наличии не откладывать визит к специалисту.

Проверка гемоглобина в лабораторных и домашних условиях
Для выявления причины недомогания врач направляет на диагностику, которая начинается со сдачи общего анализа крови. Для получения правильных результатов необходима подготовка к процедуре. Анализ сдается только утром и за 8-10 часов до него нельзя есть. Накануне нельзя употреблять алкоголь и перед процедурой курить. Об употребляемых лечебных препаратах необходимо предварительно сообщить врачу.
В тех случаях, когда ощущается незначительный дискомфорт или головокружение, можно самостоятельно провести тест, и измерить уровень гемоглобина в домашних условиях. Подготовка к тестированию должна быть аналогична лабораторной проверке. В аптеке можно приобрести специальную тест-полоску, позволяющую сделать анализ на гемоглобин. Но если симптомы повторились, надо обратиться к врачу.
Многие люди интересуются, как проверить уровень гемоглобина в домашних условиях, особенно в условиях ограниченного доступа к медицинским учреждениям. Существуют различные способы, которые позволяют получить приблизительные данные о состоянии организма. Например, некоторые используют специальные тест-полоски, которые можно приобрести в аптеке. Эти полоски позволяют быстро определить уровень гемоглобина, просто капнув немного крови на тест.
Другие предпочитают более традиционные методы, такие как анализы, которые можно провести с помощью домашних наборов. Однако важно помнить, что такие тесты не всегда могут заменить профессиональную диагностику. Пользователи часто делятся своим опытом в интернете, обсуждая точность и удобство различных методов. В целом, многие отмечают, что домашние тесты могут быть полезны для мониторинга состояния здоровья, но не заменяют консультации с врачом при наличии серьезных симптомов или заболеваний.
Многие люди интересуются, как проверить уровень гемоглобина в домашних условиях, и делятся своим опытом. Одним из самых популярных способов является использование портативных анализаторов крови, которые позволяют получить результат всего за несколько минут. Пользователи отмечают, что такие устройства просты в использовании и дают достаточно точные результаты.
Некоторые предпочитают проверять уровень гемоглобина с помощью тест-полосок, которые можно приобрести в аптеке. Однако важно помнить, что для получения достоверных данных необходимо следовать инструкциям и учитывать время суток, когда проводится тест.
Многие также советуют следить за симптомами, такими как усталость, головокружение или бледность кожи, которые могут указывать на низкий уровень гемоглобина. В таких случаях стоит обратиться к врачу для более точной диагностики. В целом, домашние методы проверки гемоглобина становятся все более доступными, что позволяет людям заботиться о своем здоровье более активно.
Показатели уровня гемоглобина
Концентрация железосодержащего белка измеряется в граммах на литр. У мужчин – 120-150 г/л, женщин – 110-140 г/л, у беременных женщин 112-165 г/л в зависимости от срока, детей до 18 лет – 92-140 г/л, детей до 6 месяцев – 130-220 г/л. С возрастом концентрация гемоглобина может падать. В период недомогания важно узнать уровень гемоглобина, так как уменьшение его общей концентрации приводит к анемии. Важно!
Дифференциальной диагностикой должен заниматься только специалист.
Самостоятельно повышать или понижать уровень вещества врачи не советуют, так как надо сначала нужно определить уровень гемоглобина, потом установить причину данного состояния. После этого можно приступать к комплексному лечению. Незначительно поднять железосодержащий белок можно, включив в рацион питания продукты, содержащие Fe. Это греча, мясо, печень, пророщенная пшеница и другие. Периодически измеряем показатели Hb.
Поддержание уровня гемоглобина в пределах нормы является основой крепкого здоровья. Каждый может проверить при помощи теста его уровень. Если изменения незначительны, то уровень Hb можно скорректировать. Если же измерения критичны, необходимо обратиться к врачу. В целях профилактики раз в год кровь проверяют, сдавая общий анализ. Лабораторные исследования определяют уровень железосодержащего белка. Главное – следить за здоровьем и вовремя посещать врача.

Вопрос-ответ
Какие методы существуют для проверки уровня гемоглобина в домашних условиях?
Существует несколько методов, включая использование портативных анализаторов крови, тест-полосок и наборов для самодиагностики. Портативные анализаторы позволяют получить результат за считанные минуты, в то время как тест-полоски требуют небольшого количества крови и могут быть менее точными.
Как часто следует проверять уровень гемоглобина дома?
Частота проверки зависит от индивидуальных факторов, таких как наличие анемии, хронических заболеваний или других состояний. Обычно рекомендуется проверять уровень гемоглобина раз в несколько месяцев, но при наличии симптомов анемии или других проблем с кровью следует делать это чаще.
Что делать, если уровень гемоглобина ниже нормы?
Если уровень гемоглобина ниже нормы, важно обратиться к врачу для дальнейшего обследования и диагностики. Врач может рекомендовать изменения в диете, добавление железосодержащих препаратов или другие методы лечения в зависимости от причины низкого уровня гемоглобина.
Советы
СОВЕТ №1
Используйте тест-полоски для определения уровня гемоглобина. Эти устройства просты в использовании и позволяют получить быстрые результаты. Просто следуйте инструкциям на упаковке, чтобы правильно провести тест и интерпретировать результаты.
СОВЕТ №2
Регулярно проверяйте уровень гемоглобина, особенно если у вас есть предрасположенность к анемии или другие заболевания, влияющие на кровь. Это поможет вам своевременно выявить проблемы и обратиться к врачу для дальнейшего обследования.
СОВЕТ №3
Обратите внимание на симптомы низкого уровня гемоглобина, такие как усталость, слабость, головокружение и бледность кожи. Если вы заметили у себя эти признаки, не откладывайте визит к врачу, даже если результаты домашнего теста находятся в норме.
СОВЕТ №4
Соблюдайте правильную диету, богатую железом и витаминами, которые способствуют усвоению железа, такими как витамин C. Это поможет поддерживать уровень гемоглобина на оптимальном уровне и улучшить общее состояние здоровья.